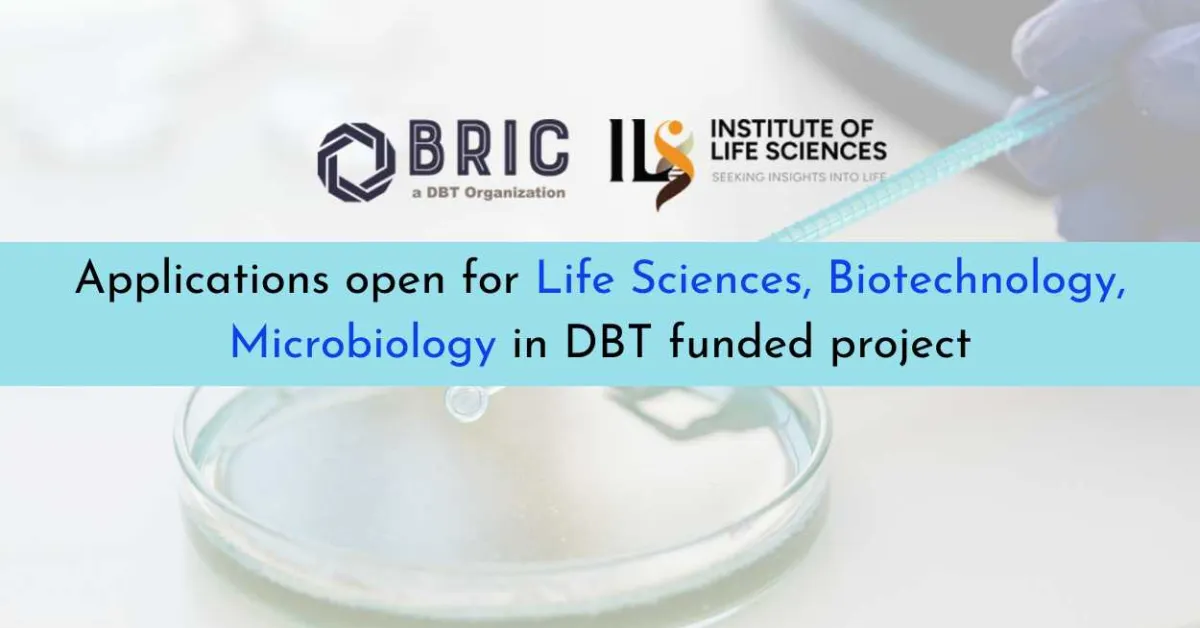
Applications open for Life Sciences, Biotechnology, Microbiology in funded project, ILS

Institute of Life Sciences (ILS), Bhubaneswar, an autonomous institute of the Department of Biotechnology, Ministry of Science & Technology, Government of India invites applications from Indian Nationals to join in the following positions coterminous with the project duration.
Post : Project Associate II (01 position)
Project title : DBT funded project ‘Investigating viroporins essential for viral assembly as targets for antiviral design’.
Principal Investigator : Dr. Soma Chattopadhyay
Duration : Upto May’ 2027
Fellowship : Rs. 35,000/- + HRA@16%
Eligibility : Master’s degree in Biotechnology, Microbiology, life sciences and allied branches and having CSIR-UGC NET-JRF/NET-LS/GATE qualification with at least 2 years of Research experience are eligible to apply. Candidates with prior experience in virology, molecular biology, cell biology, biochemistry, animal handing and BSL-3 laboratory related works will be preferred.
Age Limit : The candidate should be below 35 years in age, as on the date of advertisement. Age relaxation will be given to the candidates as per Govt. of India rules.
The interested/eligible candidates may download application form from our website ils.res.in and attend the interview with the complete application form along with attested copies of mark sheets and certificates, age proof, caste certificate (if any), along with the Curriculum vitae (CV) and experience certificate. Incomplete applications and applications without the above-mentioned documents will be rejected.
No TA/DA will be paid for attending the interview. The decision of the Director regarding the selection of candidates will be final and no further correspondence will be entertained in this regard.
Walk-in interview : 02/02/2026 from 10.00 am onwards
Venue : Institute of Life Sciences (ILS)-S+5, 1st Floor Meeting room, Nalco Square, Bhubaneswar
Note : All communication will be through e-mail (Technical support: app@ils.res.in other queries: academics@ils.res.in). No separate call letter will be issued to the candidates.
See All Bhubaneswar Alerts D.Pharm Alerts B.Pharm Alerts M.Pharm Alerts
See All Other Jobs in our Database
Subscribe to Pharmatutor Job Alerts by Email